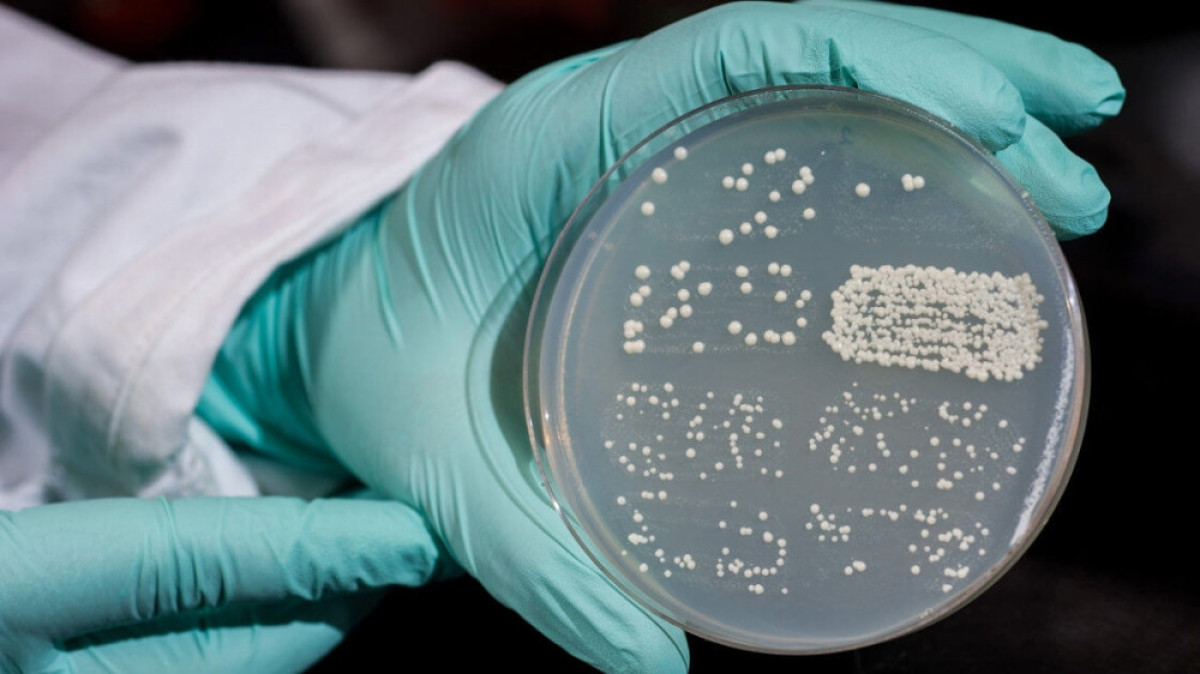
из открытых источников

Появились результаты проверки заведений питания, где после отравления умерла трёхлетняя девочка в Шымкенте, передаёт корреспондент BNews.kz со ссылкой на Sputnik.
Специалисты высеяли микроб в остатках пиццы, которую мама погибшей заказала через интернет. Смывы с ручки домашнего крана и ножа на бактерии группы кишечной палочки рода протей дали положительный результат.
Напомним, после похода в кафе, пострадавшие заказали суши и пиццу в интернете.
"Мы данное заведение, которое осуществило доставку, проверили. Из отобранных пищевых продуктов в суши "Филадельфия" высеяна бактерия кишечной группы. Из смывов - четыре положительные", - рассказали в департаменте охраны общественного здоровья Туркестанской области.
Кроме того, микроб рода протей был высеян из промывных вод матери и ребенка.
Стоит отметить, что эксперты также проверили местное кафе, в котором обедала девочка. На бактериологическое исследование отобрали пробы еды, котрую она употребляла, все они оказались "чистыми".
При этом, у пяти работников пищеблока - двух поваров, помощника повара, посудомойщицы и кондитера обнаружили золотистый стафилококк.
В настоящее время от работы отстранены 15 работников кафе и три сотрудника заведения, которые осуществляют доставку суши и пиццы. Как оказалось, у них не было медицинских книжек. Также были составлены административные протоколы в виде штрафов.
Информация о результатах проверки находится в органах внутренних дел.
Напомним, 10 сентября в Шымкенте после похода в кафе скончалась трёхлетняя девочка. Ребёнок поступил в больницу с жалобами на рвоту и боли в животе.
После этого, в инфекционной больнице, где лежал ребёнок, начались проверки.
 Тамила Языкова
Тамила Языкова